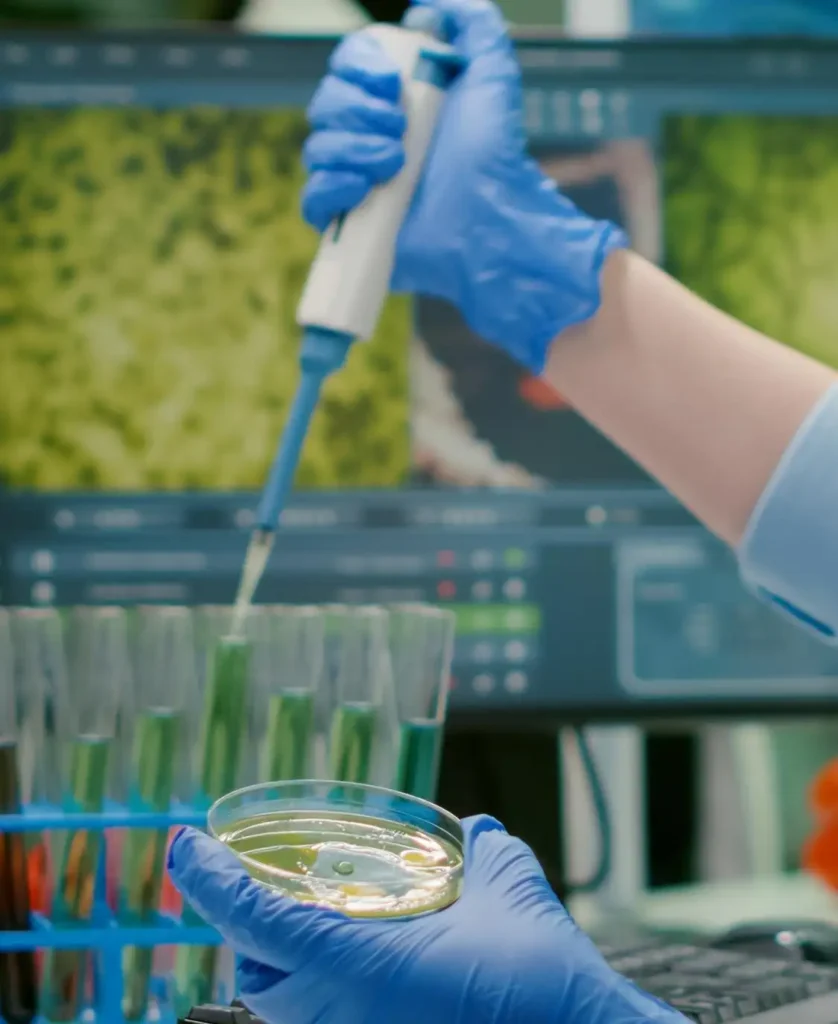

About us
Company Overview
Finelab and Environmental Consultancy LLC (FineLab) is a prominent environmental consultancy firm situated in ICAD I, Abu Dhabi, UAE.
FineLab operates as a multidisciplinary environmental consultancy and laboratory service provider within the UAE. We offer comprehensive environmental solutions aimed at fostering sustainable development, ensuring regulatory compliance, and enhancing operational efficiency across various sectors such as oil & gas, infrastructure, industrial facilities, real estate, and governmental organizations.
Our team comprises seasoned environmental scientists, engineers, ecologists, and auditors who integrate regulatory expertise with technical proficiency and accredited laboratory testing to deliver precise, dependable, and actionable environmental services to our clients.
Our objective is to assist clients in fulfilling their environmental, social, and governance (ESG) obligations while safeguarding natural ecosystems and adhering to standards set by EAD, ADNOC COPs, IFC, WHO, and ISO.
We uphold the quality of our services in accordance with ISO 9001, ISO 14001, ISO 45001, ISO 17025:2017, and ISO 17020 standards. Recently, we received approval from the Environmental Agency Abu Dhabi. FineLab stands out as a trusted partner in environmental consultancy.
Company Mission & Vision
Mission:
We at FineLab and Environmental Consultancy LLC, our mission is to empower organizations and communities to achieve sustainability and environmental stewardship. And to provide accurate, reliable, and timely testing services that meet the highest standards of quality and integrity. We are committed to exceeding customer expectations, fostering innovation, and contributing to the advancement of industries in the UAE and beyond.
Vision:
We provide expert environmental consulting services that drive innovation, reduce environmental impact, and promote eco-friendly practices. Our team is dedicated to delivering high-quality, client-focused solutions that support a healthier planet and a more sustainable future." Our dedicated team of environmental engineers, Microbiologist and Chemist are experts, dedicated to delivering exceptional service, ensuring compliance with regulatory requirements of ISO 17025 and ISO 17020 standards, and promote a culture of continuous improvement.

Certifications & Approvals



